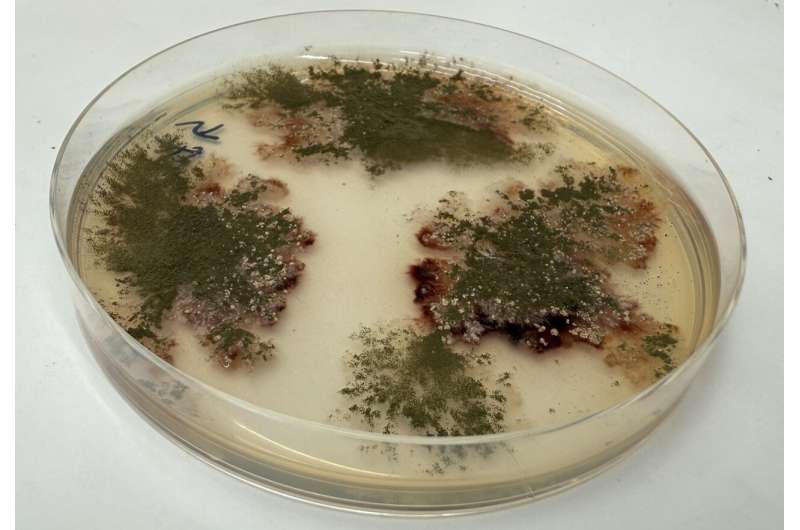
从工程化真菌分子到药物先导：化学-生物混合合成助力抗寄生虫药物发现

阿米巴病是一种由溶组织内阿米巴引起的寄生虫感染,主要通过受污染的水或食物传播。全球每年约有5000万有症状病例,在热带和亚热带地区尤为常见。
烟曲霉素作为一种真菌天然产物,长期被研究用于抗寄生虫治疗,但其类似物卵泡菌素因体内快速代谢而未开发。近期发表于《美国化学学会杂志》的研究显示,卵泡菌素虽对阿米巴病有效,但肝脏酶会迅速分解它。名古屋大学生物农业科学研究生院的科学家采用化学-生物混合合成方法,开发出代谢稳定的候选药物,在动物模型中成功治疗了包括肝脏脓肿在内的感染。
研究团队识别出负责卵泡菌素分解的肝脏细胞色素P450酶,CYP 2B1和CYP 2C6是主要作用者。通过化学抑制剂阻断这些酶,显著延长了卵泡菌素的存活时间,证实快速代谢限制了其药效。
资深作者常松裕太副教授表示:“我们通过工程化真菌构建了修饰的卵泡菌素分子,具有可定制的连接点。连接不同分子基团后,我们创造出肝脏无法破坏的版本。”利用基因工程丝状真菌,团队生产了克级非天然卵泡菌素,并测试约30种衍生物,以筛选出能杀灭寄生虫、耐受代谢且无毒的化合物。
原生动物寄生虫依赖MetAP2酶维持生存,阻断该酶可杀死寄生虫而不影响人类,因人体有备用酶。新化合物YOK24和NS-181有效抑制了寄生虫的MetAP2酶,在仓鼠模型中消除了感染和肝脏脓肿。
这些成果为人体测试奠定了基础,化合物在注射和口服给药中均有效,口服治疗特别适合资源匮乏的阿米巴病高发地区。当前治疗方法如甲硝唑可能引起副作用并面临耐药性挑战。化学-生物混合合成结合了基因工程和化学技术,将实验室有效但体内不稳定的天然化合物转化为实用药物,有望应用于其他寄生虫病、癌症和肥胖的治疗。
出版详情:作者:Nagoya University;标题:《From engineered fungal molecules to drug leads, chem-bio hybrid synthesis enables antiparasitic drug discovery》;发表于:《Journal of the American Chemical Society》(2026)。
